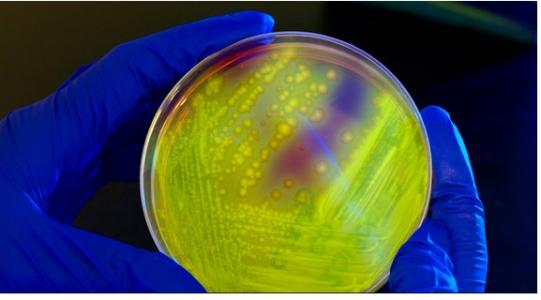
n plaidoyer de plus pour une thérapie encore mal acceptée par les patients mais qui progresse sur ce point avec de nouvelle formes d’administration comme la « poop pill ».

Transplantation du MICROBIOTE FÉCAL : Un traitement efficace et économique contre C. difficile
Le traitement par greffe ou transplantation de microbiote fécal permet de raccourcir de 37 jours à seulement 20 jours par an, la durée d’hospitalisation liée au traitement de la colite à Clostridium difficile, montre cette étude de l’Université d'Aarhus (Danemark), présentée dans la revue Therapeutic Advances in Gastroenterology. Un plaidoyer de plus pour une thérapie encore mal acceptée par les patients mais qui progresse sur ce point avec de nouvelle formes d’administration comme la « poop pill ».
Pourtant, la transplantation de microbiote fécal a fait déjà ses preuves et la thérapie peut même sauver des vies. De plus, le traitement semble permettre d’importantes économies de coûts de santé. Cette étude observationnelle menée sur une cinquantaine de patients ajoute aux preuves de l’efficacité de ce nouveau type de greffe, contre la colite à Clostridium difficile.
17 jours d’hospitalisation en moins : l’étude montre qu'en moyenne, les patients traités ont évité 17 jours d'hospitalisation durant la première année suivant leur transplantation fécale, passant d'une durée d’hospitalisation de 37 jours par an à 20 jours en moyenne. Mais ce n’est pas tout : les coûts hospitaliers ont été réduits de 42% soit un coût moyen par patient réduit de 56.400 à 32.800 €/an. Cette économie sur l’année et par patient comprenant les coûts d'hospitalisation, des traitements antibiotiques et de la transplantation.
Ces données viennent confirmer la transplantation de matières fécales comme un nouveau traitement extrêmement efficace. « Nous avons ici une forme de traitement qui, en plus, fait économiser à la société des millions d'euros chaque mois.
Autres actualités sur le même thème
APNÉE du sommeil : La santé intestinale en cause ?
Actualité publiée il y a 10 mois 4 semainesTROUBLES de l’HUMEUR : Vers le concept de psychobiotiques ?
Actualité publiée il y a 5 années 3 moisMICROBIOTE et ÉVOLUTION : Mais comment a-t-on fait pour vivre avec tous ces microbes ?
Actualité publiée il y a 7 années 6 moisMICROBIOTE et ANTIBIORÉSISTANCE : Découverte dans l’intestin de 6.000 gènes de résistance
Actualité publiée il y a 7 années 3 mois




